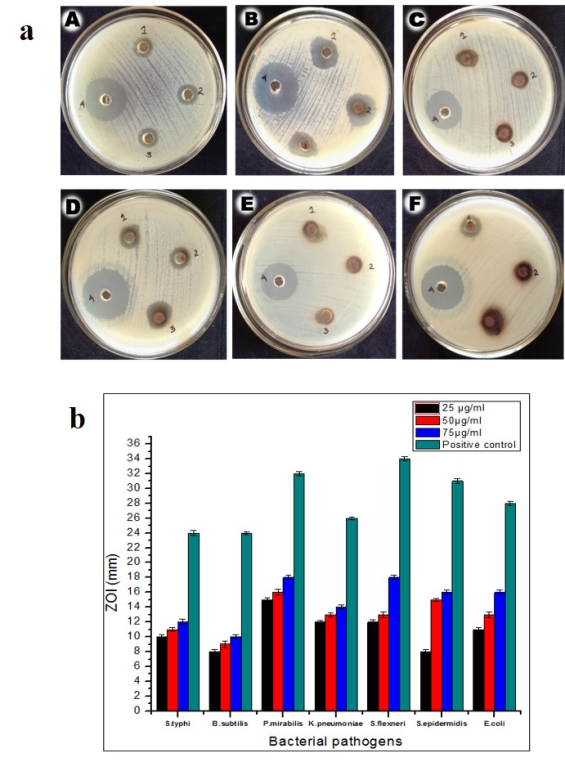

Int J App Pharm, Vol 8, Issue 4, 2016, 43-46Original Article
ASPERGILLUS FLAVUS MEDIATED SILVER NANOPARTICLES SYNTHESIS AND EVALUATION OF ITS ANTIMICROBIAL ACTIVITY AGAINST DIFFERENT HUMAN PATHOGENS
A. WILSON, S. PRABUKUMAR, G. SATHISHKUMAR, S. SIVARAMAKRISHNAN*
Department of Biotechnology, Bharathidasan University, Tiruchirappalli 620024, Tamilnadu, India
Email: sivaramakrishnan123@gmail.com
Received: 06 Jul 2016, Revised and Accepted: 12 Sep 2016
ABSTRACT
Objective: Here, we report the extracellular synthesis of silver nanoparticles (AgNPs) using the cell-free extract of fungal isolate Aspergillus flavus and evaluation its inhibitory activity against bacterial pathogens.
Methods: Synthesized AgNPs was characterized via high throughput instrumentation such as UV–Visible spectrophotometer (UV-Vis) and Fourier transform infrared spectroscopy, High-resolution transmission electron microscopy (HRTEM), X-ray Diffraction (XRD) and Energy dispersive X-ray spectroscopy (EDAX).
Results: Formation of yellowish brown colour clearly indicates the synthesis of AgNPs which produces a SPR peak at 420 nm. Active protein metabolites present in the cell-free extract plays a crucial role in reduction and stabilization of AgNPs. It was clearly observed that synthesized AgNPs were faced-centered cubic crystalline in nature with the mean size of 22±11 nm. Further, synthesized AgNPs capped with protein moieties exhibits excellent inhibitory activity against tested bacterial pathogens.
Conclusion: In this study, we have isolated the fungal strain A. flavus from the infected larvae of D. eucharis from the soil. The active metabolites of isolated A. flavus have been successfully used as an eco-friendly reducing agent to generate AgNPs and synthesized particles can be potentially developed as a drug candidature for antimicrobial therapy.
Keywords: A. flavus, Silver nanoparticles, HRTEM, Proteins, Human pathogens
© 2016 The Authors. Published by Innovare Academic Sciences Pvt Ltd. This is an open access article under the CC BY license (http://creativecommons.org/licenses/by/4.0/)
DOI: http://dx.doi.org/10.22159/ijap.2016v8i4.13930
INTRODUCTION
In recent times, nanotechnology is being considered as an impressive technology through which various nanosystems with improved size, distribution, and morphology have been developed for advanced biomedical applications. Especially, nanostructures of noble metals such as silver, platinum, gold and palladium have received huge attention due to their specific physical, chemical, optical, electronic, magnetic and mechanical properties [1].
Generally, materials at nanoscale level have been fabricated routinely either “top-down or “bottom-up” approaches. Most of the physical and chemical methods of nanoparticles synthesis were too expensive and involved with the utilization of toxic chemicals which is hazardous to the environment and its associated life forms. Now, a new innovative route using different biological entities such as plants, microbes, yeast, and actinomycetes have been developed as an alternative eco-friendly approach [2].
There are several routes to reach metal nanoformulations like sonochemical, thermal decomposition, microwave irradiation (electrochemical, ablation, chemical reduction, and recently green synthesis. Unfortunately, many of the nanoparticle synthesis or production methodologies are persists with the use hazardous chemicals, low material conversions, high energy requirements and difficulty in purifications on the major contaminants [3]. Therefore, there is a growing need to develop environmental friendly processes for nanoparticle synthesis without disturbing the environment and its associated life forms.
In general, microorganisms were widely exploited for various commercial biotechnological processes such as bioleaching and bioremediation to extract metals from the ores. These unicellular organisms hold the tendency to produce inorganic metal nanoparticles either intra-or extracellularly with unique physiochemical properties. It was recognized that generation of nanoparticles occurs after the conversion metal ions into an element in the presence of microbial enzymes either inside the cell or on the surface of the cell [4].
Interestingly, in the case of biological synthesis, the interaction between nanomaterials with active metabolites provides functionalized hybrid nanomaterials. A number of fungal species such as Cochliobolus lunatus, Fusarium oxysporum, Aspergillus fumigate, Aspergillus niger, Aspergillus clavatus, Epicoccum nigrum, Amylomyces rouxii [5-11] have been screened for their nanobiotechnological potential with noble metals such as silver and gold.
Moreover, development of microbial resistance, the prospectus to manage the public health crisis has worsened drastically. Although several new antibiotics have been developed in the last few decades, none of them have been found with improved activity against multidrug-resistant pathogenic organisms. Therefore, it is imperative to design better therapeutic strategies, including new antibiotics [12]. Hence, the present study was focused on a native fungal strain A. flavus isolated from infected cadavers of butterfly Delias eucharis larvae, and assessed for the synthesis of AgNPs for antimicrobial potentials.
MATERIALS AND METHODS
Materials
Silver nitrate (AgNO3) and other chemicals were purchased from Himedia Laboratories, Mumbai, India. The infected cadavers of butterfly (Delias eucharis) larvae were collected from Bharathidasan university campus, Tiruchirappalli, Tamilnadu.
Methods
Isolation and identification of A. flavus
A native fungal strain was isolated from the infected cadavers of butterfly (Delias eucharis) larvae. Initially, strain was plated on martin rose bengal agar media and plates were incubated at 28 °C for 4 d. Individual colonies were picked and further purified by using potato dextrose agar (PDA) media. Morphological and microscopic observation (such as colour, texture of mycelia, spore formation pattern, etc.,) were made for recovered strain; further genomic DNA was isolated by CTAB method [13] according to the stranded protocol. The internal transcribed spacer (ITS) amplified primer ITS1 and ITS4 with 5´-TCCGTAGGTGAACCTGCGG-3´ and 5´-TCCTCCGCTTATTGATATGC-3´ sequences respectively and PCR amplified product were sequenced. Finally, the resulting sequence was entered into BLAST algorithm of National Centre of Biological Information (NCBI) database for closely related phylogenetic sequences. The phylogenetic tree was constructed through maximum likelihood method in Mega 6.0 software.
Synthesis of AgNPs
A. flavus was maintained on PDA slants for 28 °C with regular sub-culture of fresh media. The stock culture of A. flavus was inoculated in 500 ml SDA (Sabouraud Dextrose Agar) and incubated in 28±1 °C for 1week. Then, the biomass was separated by whatman filter paper No.1. The reaction mixture for the synthesis of AgNPs was prepared by blending 10 ml of the fungal extracts to 90 ml of 1 mmol AgNO3 solution in a 250 ml conical flask and incubated at 29 °C for reduction.
Characterization of AgNPs
The myco-synthesized AgNPs was initially confirmed by measuring the absorbance spectra using UV-Vis spectroscopy in the wavelength range between300-700 nm in JASCO V-650 spectrophotometer. Synthesized AgNPs was stored at room temperature for 90 d to check its stability. FTIR-Spectroscopic analysis was carried out to find the possible bio-reducing agent present in the fungus (A. flavus) responsible for reduction and stabilization of AgNPs. For that, the sample was mixed with KBr powder and pelletized after drying the spectra were recorded using Perkin Elmer make model spectrum RX1 (wavelength range between 4000 cm-1 and 400 cm-1). X-ray diffraction measurements of AgNPs were carried on XRD 600, Shimadzu, Japan instruments operating at a voltage of 40Kv and current of 30mA with CuK radiation. To perform TEM analysis, a drop of aqueous solution containing the AgNPs sampled onto carbon coated copper grids and dried under an infrared lamp. TEM observations were made with TECNAI-10 operated at an accelerating voltage at 100kv. In addition, to check the purity and presence of metal (Ag)in the sample (AgNPs) EDAX analysis was executed.
Screening of antimicrobial activity
The antibacterial activity of AgNPs was evaluated by agar well diffusion method [14] against human pathogenic bacteria such as E. coli, B. subtilis, E. faecalis, S. flexneri, K. pnemoniae, S. epidermis and P. mirabilis in the Mueller-Hinton agar media (MHA) with different concentration of AgNPs (25, 50 and 100 μg/ml). Streptomycin sulphate was used as a control. After 24 h incubation at 37 °C, a zone of inhibition (ZOI) was measured and the diameters of ZOI were measured using a meter ruler. The assay was done in triplicate, and the results were given in mean±SD.
RESULTS AND DISCUSSION
Isolation and molecular identification of A. flavus
In general, fungi are beneficial than other biological agents for AgNPs synthesis as demeanour great metal uptake and lenience and well binding ability [16].

Fig. 1: a. Morphology of isolated fungi A. flavus b. Phylogenetic analysis of fungal isolated from the infected cadaver. The phylogenetic tree was constructed based on ITS-1 and ITS-4 sequences using the maximum parsimony method in MEGA ver. 5.2. The percentage of replicate trees in which the associated taxa clustered together in the bootstrap test (1,000 replicates) is shown next to the branch
Additionally, myco-synthesized AgNPs have good monodispersed, controlled size, and shape with hydrophilic nature [17]. In this study, A. flavus was isolated from the infected cadaver of D. eucharis butterfly. We have used the conidia and mycelia morphology to for preliminary confirmation (fig. 1a) and further it was confirmed by rDNA sequence analysis. The sequence was then aligned with the CLUSTAL W program and later the aligned sequence was subjected to phylogenetic tree construction based on the neighbour joining method encompassing with 1000 bootstrap replications (fig. 1b). In the phylogenetic tree, the species were clustered into their respective genus clade. This revealed that the isolated fungal sequences showed 98% homology with A. flavus.
Synthesis of AgNPs
The fungal extracellular filtrate was added with 1 m mol AgNO3 solution, after 24-72 h incubation the appearance of brown colour has strongly confirmed the synthesis of AgNPs in the reaction mixture (fig. 2a). The appearance of the dark brown colour was due to the excitation of surface plasmonic resonance (SPR), which is a characteristic feature of AgNPs [18].

Fig. 2: a. Development of yellowish brown color indicates the generation of AgNPs b. Synthesized AgNPs produces intense absorbance spectra 420 nm in UV-Visible spectroscopy
Characterization of AgNPs
It was generally recognized that UV–Vis spectroscopy could be used to study the size and shape of nanoparticles in suspensions [19]. The SPR of AgNPs were characteristics an absorbance spectrum in the visible area of electromagnetic radiation at 420 nm which is recorded in UV–Visible spectrophotometer (fig. 2b). FTIR analysis shows the transmittance at 3464 cm-1, 2077 cm-1, 1637 cm-1 and 679 cm-1which indicates the functional group of the fungal compounds which involves in the reduction of AgNPs (fig. 3a). The transmittance attributes O-H stretch, C=C bond and C-H which reveals that the water soluble heterocyclic components and certain proteins existing in the filtrate actively involved in the reduction of silver nitrate. Similar phenomenon has been reported earlier [20], where it was clealy mentioned that these active protein biomolecules present in the culture filterate of the act as reducing and capping agent. XRD analysis was carried out to determine the crystalline nature of myco-synthesized AgNPs. X-ray diffractogram intensities were interpreted with JCPDS which shows the diffraction planes at (111), (200), (220) and (311) depicts that myco synthesized AgNPs were cubic crystalline in nature (fig. 3b). Our result highly matches with many earlier reports which shows XRD 2θ values that corresponding to the face cantered cubic structure of AgNPs [21].

Fig. 3: a. FTIR spectra of myco synthesized AgNPs shows the presence of protein moieties as capping agent b. XRD analysis of AgNPs
TEM images shows the precise size, shape and morphology of myco-synthesized AgNPs (fig. 4a). It displays spherical AgNPs with the size range between with an average size of.,the particles were well dispersed, and no direct contact was noticed mainly due to the presence of the capping agent. EDAX analysis shows a strong metal peak for Ag at 3 keV presence of a copper metal peak is due to grid used for the analysis (fig. 4b).

Fig. 4: a. TEM-Analysis of myco synthesized AgNPs; b. EDAX analysis myco synthesized AgNPs
In the fig. 4b, the elemental analysis of AgNPs revealed the highest proportion of silver which suggests the present of Ag as the major ingredient element followed by carbon and oxygen metal elements.
Antibacterial activity
Smaller particles with a more surface range have greater antibacterial effects compared to larger particles [22]. The antimicrobial efficacy of myco synthesized AgNPs was assessed against various pathogens. Synthesized AgNPs showed potential antibacterial activity against all tested pathogens like E. coli, B. subtilis, S. flexneri, E. faecalis,K. pnemoniae, S. epidermis and P. mirabilis. It was observed that increased concentration of AgNPs (75 μg/ml) inhibits the bacterial growth progressively (fig. 5a and b).
Fig. 5: a. Antibacterial activity of AgNPs against human pathogens A-K. pnemoniae, B-P. mirabilis, C-S. typhi, D-S. flexneri, E-B. subtilis, E-E. faecalis, F-E. coli Concentrations: 1-25 µg/ml; 2-50 µg/ml; 3-75μg/ml; 4-antibiotics. b. Antimicrobial activity of AgNPs against bacterial pathogens. The test was performed in triplicate and the results were given in mean±SD
This eminent antibacterial activity of AgNPs is owed to its expert surface property [19]. The highest zone of inhibition was observed against P. mirabilis and S. flexneri at the concentration of 100µg/ml. Lowest zone of inhibition against the B. subtilis and S. epidermis (7 mm). When concentration is increased the activity of AgNPs was also getting improved. Furthermore, Ag is acidic in nature, requiring the trend to respond with bases,when AgNPs react with DNA containing sulfur and phosphorous groups it eradicates the DNA or failure of respiratory chain reaction [23].
CONCLUSION
In the present study, a native fungal strain was successfully isolated from a novel habitat D. eucaris infected cadavers. The isolated fungal strain was identified as A. flavus based on its morphological and molecular characterization. The culture filterate of A. flavus was efficaciously used as straight bio-reductant to convert Ag+into Ag °. Myco-synthesised AgNPs were characterized by UV–vis spectroscopy, FTIR, XRD and HRTEM which visibly portrays the formation of highly stable face-centered cubic AgNPs. Further, the myco-synthesized AgNPs was very promising and showed excellent antibacterial activity against human bacterial pathogens. Based on the results it was proposed that myco-synthesised AgNPs can be developed as a potential nanomaterial for biomedical applications.
CONFLICT OF INTERESTS
Declare none
REFERENCES
- Zhao S, Gorte RJ. The activity of Fe–Pd alloys for the water-gas shift reaction. Catal Lett 2004;92:75–80.
- Devi LS, Joshi SR. Evaluation of the antimicrobial potency of silver nanoparticles biosynthesized by using an endophytic fungus, Cryptosporiopsis ericae PS4. J Microbiol 2014;52:667-74.
- Sathishkumar G, Bharti R, Jha PK, Selvakumar M, Dey G, Jha R, et al. Dietary flavone chrysin (5, 7-dihydroxyflavone ChR) functionalized highly-stable metal nanoformulations for improved anticancer applications. RSC Adv 2015;5:89869-78.
- Narayanan KB, Sakthivel N. Biological synthesis of metal nanoparticles by microbes. Adv Colloid Interface Sci 2010;156:1–13.
- Rahul BS, Satish VP, Chandrashekhar DP, Bipinchandra KS. The larvicidal potential of silver nanoparticles synthesized using fungus Cochliobolus lunatus against Aedes aegypti (Linnaeus, 1762) and Anopheles stephensi Liston (Diptera; Culicidae). Parasitol Res 2011;109:823–31.
- Ahmad A, Mukherjee P, Senapati S, Mandal D, Khan MI, Kumar R, et al. Extracellular biosynthesis of AgNPs using the fungus Fusarium oxysporum. Colloids Surf B 2003;28:313–8.
- Bhainsa KC, D’Souza SK. Extracellular biosynthesis of AgNPs using the fungus Aspergillus fumigates. Colloids Surf B 2006;47:160–4.
- Gade AK, Bonde P, Ingle AP, Marcato PD, Duran N, Rai MK. Exploitation of Aspergillus niger for the synthesis of AgNPs. J Biobased Mater Bioenergy 2008;2:243-7.
- Verma VC, Kharwar RN, Gange AC. Biosynthesis of antimicrobial AgNPs by the endophytic fungus Aspergillus clavatus. Nanomedicine 2010;5:33–40.
- Qian Y, Yu H, He D, Yang H, Wang W, Wan X, et al. Biosynthesis of AgNPs by the endophytic fungus Epicoccum nigrum and their activity against pathogenic fungi. Bioprocess Biosyst Eng 2013;36:1613–9.
- Musarrat J, Dwivedi S, Singh BJ, Al-Khedhairy AA, Azam A, Naqvi A. Production of antimicrobial AgNPs in water extracts of the fungus Amylomyces rouxii strain KSU-09. Bioresour Technol 2010;101:8772–6.
- Sundararajan B, Mahendran G, Thamaraiselvi R, Kumari BDR. Biological activities of synthesized silver nanoparticles from Cardiospermum halicacabum L. Bull Mater Sci 2016;39:423–31.
- Prabukumar S, Rajkuberan C, Ravindran K, Sivaramakrishnan S. Isolation and characterization of endophytic fungi from medicinal plant Crescentia cujete l. and their antibacterial, antioxidant and anticancer properties. Int J Pharm Pharm Sci 2015;7:316-21.
- Pradeepa M, Kalidas V, Geetha N. Qualitative and quantitative phytochemical analysis and bactericidal activity of Pelargonium graveolens l’her. Int J Appl Pharm 2016;8:7-11.
- Chen JC, Lin ZH, Ma XX. Evidence of the production of silver nanoparticles via pretreatment of Phoma sp. 3.2883 with silver nitrate. Lett Appl Microbiol 2003;37:105–8.
- Mohanpuria P, Nisha K, Rana NK, Yadav SK. Biosynthesis of nanoparticles: technological concepts and future applications. J Nanopart Res 2008;10:507–17.
- Song JY, Kim BS. Rapid biological synthesis of silver nanoparticles using plant leaf extracts. Bioprocess Biosyst Eng 2009;32:79–84.
- Shrivastava S, Dash D. Label-free colorimetric estimation of proteins using nanoparticles of silver. Nano-Micro Lett 2010;2:164-8.
- MubarakAli D, Thajuddin N, Jeganathan K, Gunasekaran M. Plant extract mediated synthesis of silver and gold nanoparticles and its antibacterial activity against clinically isolated pathogens. Colloids Surf B 2011;85:360–5.
- Rajkuberan C, Prabukumar S, Sathishkumar G, Wilson A, Ravindran K, Sivaramakrishnan S. Facile synthesis of silver nanoparticles using Euphorbia anti quorum L. latex extract and evaluation of their biomedical perspectives as anticancer agents. J Saudi Chem Soc 2016. Doi:10.1016/j.jscs.2016.01.002. [Article in Press]
- Panacek A, Kvitek L, Prucek R, Kolar M, Vecerova R, Pizurova N, et al. Silver colloid nanoparticles: synthesis, characterization, and their antibacterial activity. J Phys Chem B 2006;110:16248–53.
- Sathishkumar G, Gobinath C, Karpagam K, Hemamalini V, Premkumar K, Sivaramakrishnan S. Phyto-synthesis of nanoscale silver particles using Morinda citrifolia L. and its inhibitory activity against human pathogens. Colloids Surf B 2012;95:235-40.
- Morones J, Elechiguerra J, Camacho A, Holt K, Kouri J, Ramirez J, et al. The bactericidal effect of silver nanoparticles. Nanotechnology 2005;16:2346-53.
How to cite this article
- A Wilson, S Prabukumar, G Sathishkumar, S Sivaramakrishnan. Aspergillus flavus mediated silver nanoparticles synthesis and evaluation of ITS antimicrobial activity against different human pathogens. Int J Appl Pharm 2016;8(4):43-46.